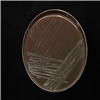

Korean Collection for Type Cultures
KCTC provides the distribution services
Find Resources
KCTC 49756
| KCTC No. | 49756 |
|---|---|
| (KCTC Other No.) | |
| Resource Type | Bacteria |
| Name | Cellulomonas xiejunii |
| Type Strain | Yes |
| Biosafty Level | 1 |
| LMO | No |
| Synonym | |
| Phylum (ex Phylum) | Actinomycetota (Actinobacteria) |
| Genome Information | |
| History | <- Lin Ye, China CDC |
| Source | From the intestinal contents of Marmot, Yushu prefecture, Qinghai Province |
| Other Collection No. | zg-B89, GDMCC [1.2821] |
| Reference | 10.1099/ijsem.0.005909 |
| KCTC Media No. |
KCTC media No. 3 Brain Heart Infusion Agar + [5% defibrillated amniotic blood] KCTC media No. 1864 BHI agar + 5% Blood |
| Oxygen Requirement | Aerobic |
| Temperature | 28 ℃ |
| pH | 7.0 |
| Incubation Time | 4 d [활성상태 계대배양 기준이므로 앰퓰, 스탁 등 장기보존체 배양의 경우 다를 수 있음] |
| Images |
|
| Price |
[Delivery form & Price]
- Freeze vial (Regular distribution): $70,000 KRW - Actively growing culture (Active culture distribution): ₩105 KRW * For regular distribution of animal cell strains to other countries, a separate dry ice fee (packing charges $500) will be added. ※ If you are picking up an animal cell strain in person, you must bring your own dry ice or liquid nitrogen. |
| MTA Restrictions | Only NON-COMMERCIAL USE for reference strains and/or academic researches |
If you use the resources sold by our KCTC for papers or patents, please make sure to write the phrase "The biological resources used in this research were distributed from KCTC"




